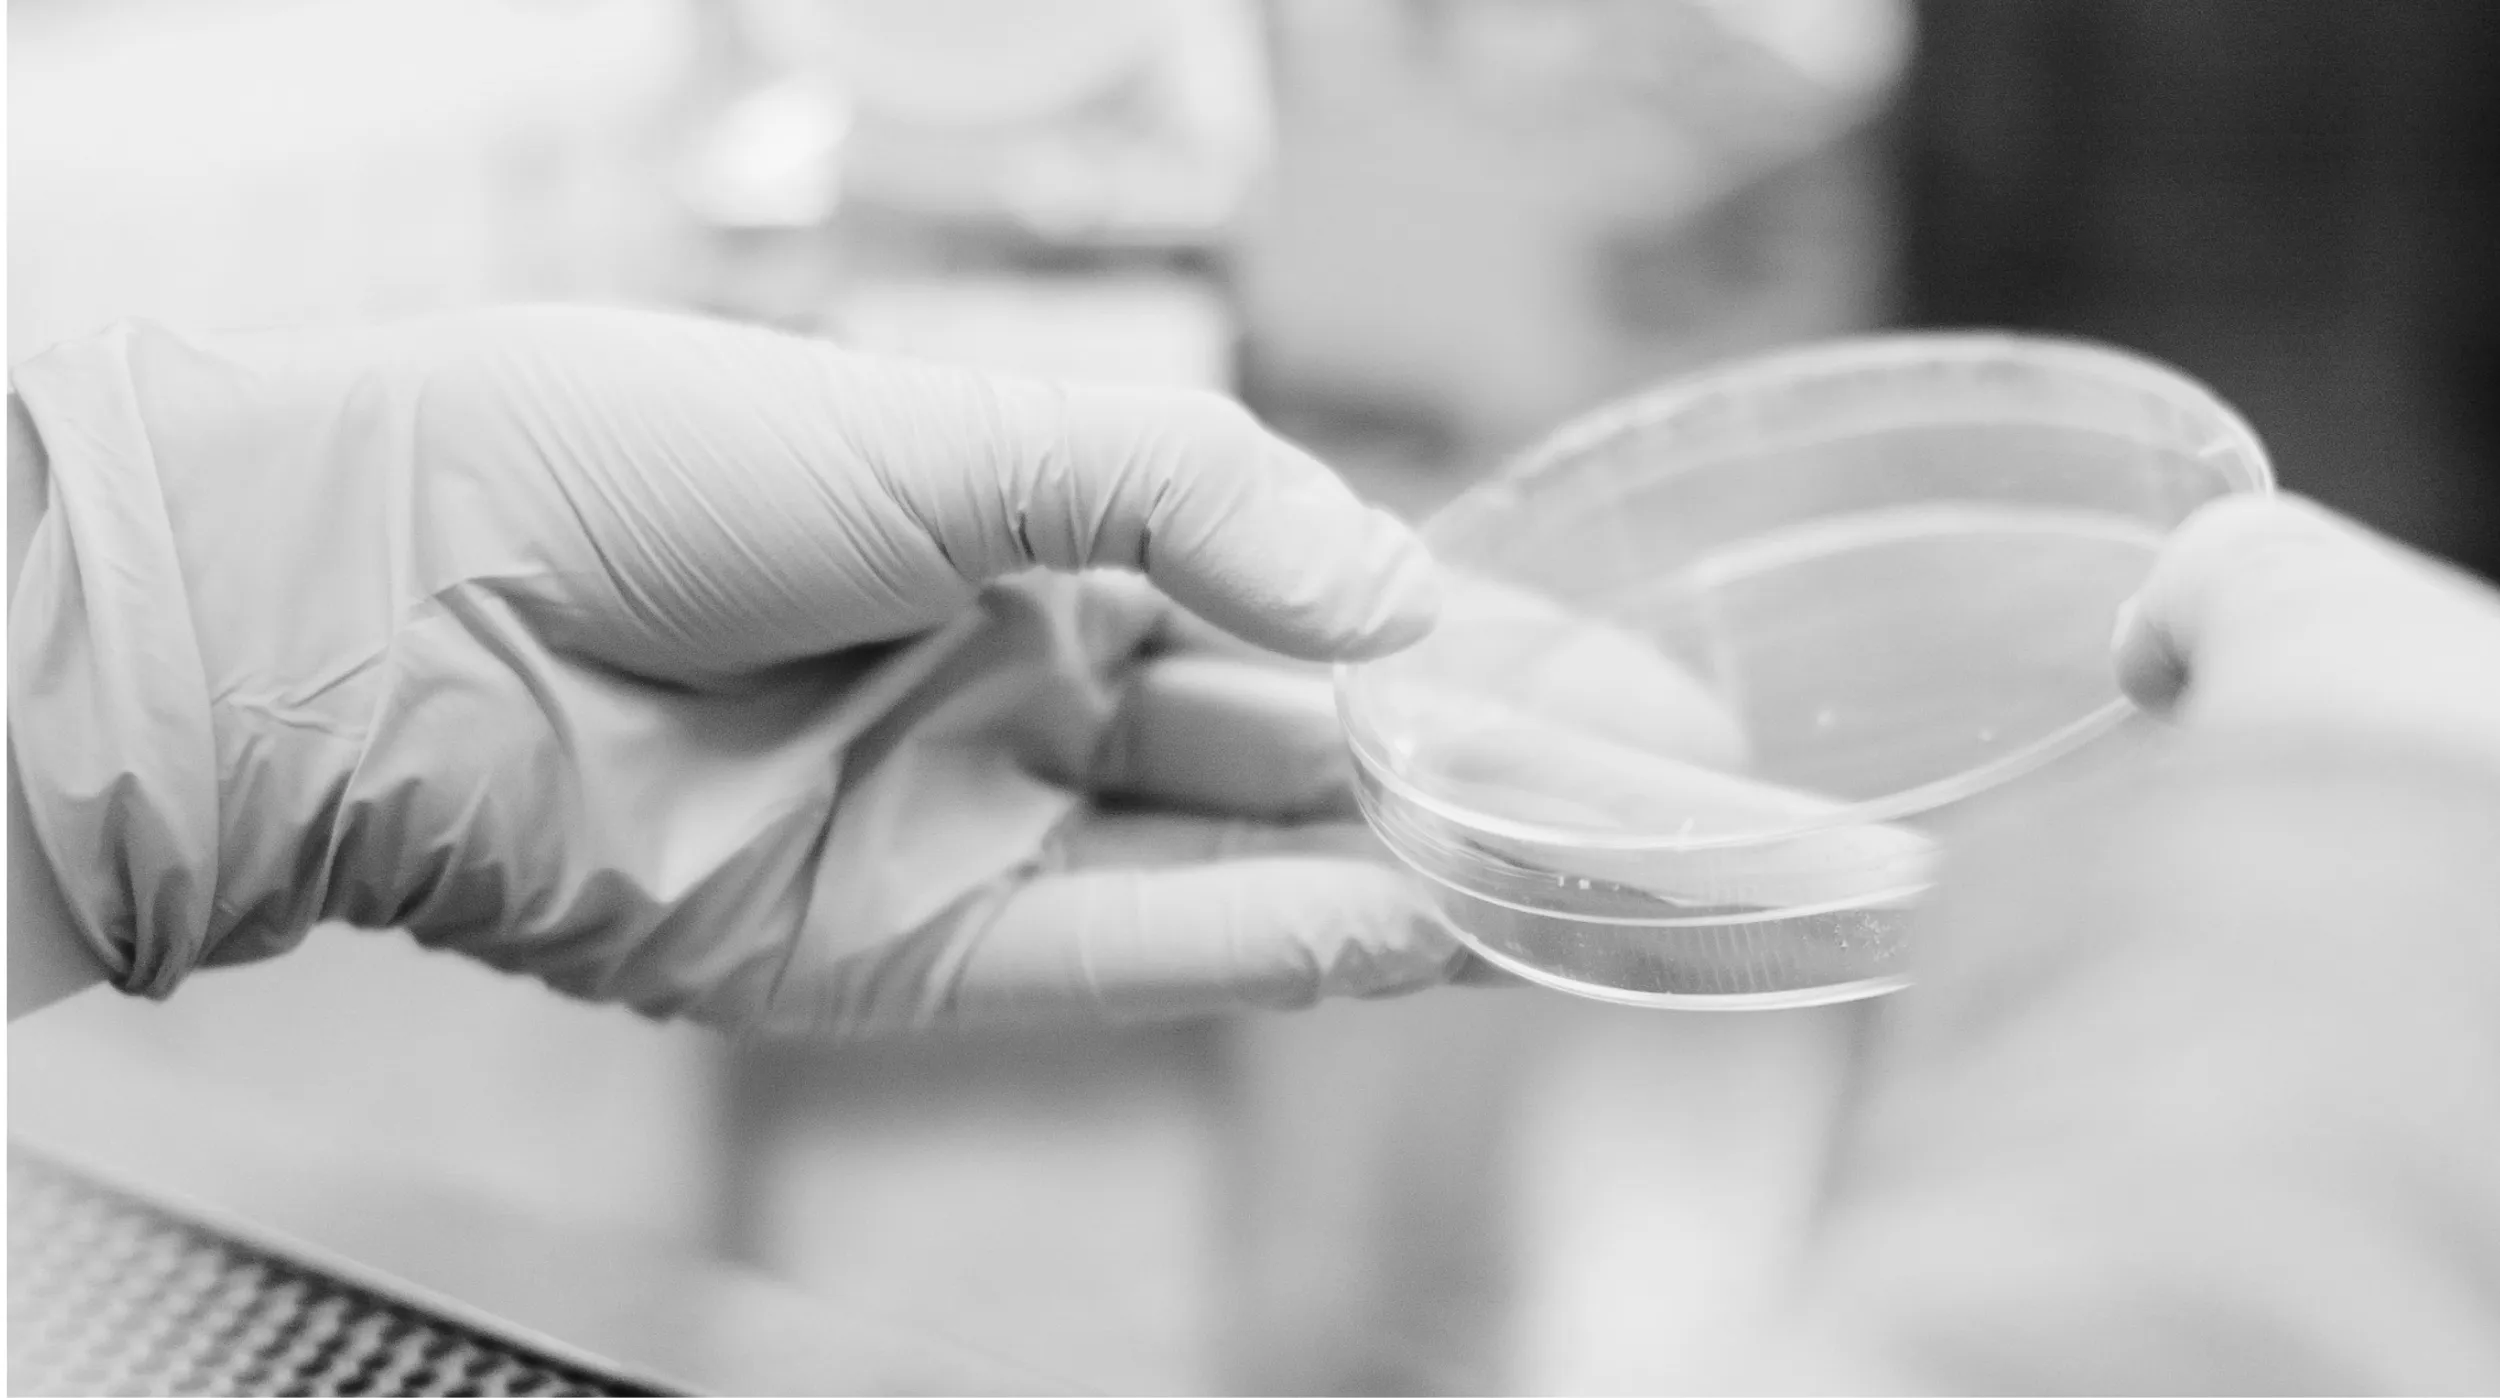

Edinburgh & Lothians
Edinburgh's startup industry has experienced remarkable growth and positioned itself as a thriving ecosystem for entrepreneurial ventures. Fueled by a vibrant mix of innovative ideas, access to talent from prestigious universities, and a supportive environment, the city has become a hotbed for startups across various sectors. Incubators, accelerators, and co-working spaces provide crucial resources, mentorship, and networking opportunities, nurturing the growth of early-stage ventures.
The startup industry in Edinburgh continues to flourish after some International success stories, SkyScanner and FanDuel, driving economic growth, innovation, and establishing the city as a prominent entrepreneurial hub.
Key industries
Digital District
CodeBase Stirling is in the centre of Stirling’s Digital District, working together with The University of Stirling, Forth Valley College, Stirling Council and the private sector to prioritise the growth of the tech community in Central Scotland. This is reflected in Central Scotland’s ecosystem with the University of Stirling curriculum providing MSc courses in Big Data, Fintech, Business and Computer Science, additionally, Forth Valley College offering cyber security and various computing courses.


Design and Games Industry
Over the last 5 years, the Stirling hub has attracted a more creative network of tenants, from founders in animation and games to videography and design. Notability Animation companies such as Wild Child and Ping Creates have celebrated a growth of expansion over the years, making Stirling the home of ‘Toad and Friends,’ ‘The Amazing World of Tom Gates,’ and the game ‘Super Stretchy Chicken Legs’ for iOS and Android.
Educational Engagement
CodeBase Stirling is in the centre of Stirling’s Digital District, working together with The University of Stirling, Forth Valley College, StirliCodeBase Stirling has historically worked with schools in the local area to engage young people in tech through facilitating and partnering with various Coding classes for children such as Level Up, Prewired and Coderdojo. In addition to creating DS4G ( Digital Skills for Girls) a free coding class for girls and non-binary young people ages 8-15.ng Council and the private sector to prioritise the growth of the tech community in Central Scotland. This is reflected in Central Scotland’s ecosystem with the University of Stirling curriculum providing MSc courses in Big Data, Fintech, Business and Computer Science, additionally, Forth Valley College offering cyber security and various computing courses.


Environmental science
The hub hosts an array of tech sectors, including that of environmental science. Landscape architects, RaeburnFarquarBowen, play an important role in our building, and also Stirling city as a whole.
Key industries
Games and Web 3.0
Dundee has a rich history in game development, with titles like Lemmings, Grand Theft Auto and Crackdown being developed within the city. This has enabled the region to become known as ‘the UK’s home of video game development’. With the likes of Outplay Entertainment and Rockstar North both having their headquarters in Dundee, it is clear that this vertical plays a major role in the city's economy. As a result there are various smaller studios within the city at various stages, some who are developing their own games, and others who provide work for hire services (mostly a mixture of both). There is also an excited movement from games into web 3.0 related products among some startups, and particular interest in this space.


Healthtech and life sciences
Thanks to university presence, there is strong support from universities helping academics and students to startup. Examples of successful startups include In4med’s app for delivering personalised care plans for patients and Exscientia using AI to automated drug discovery processes.
Cybersecurity and ethical hacking
Abertay University has invested heavily in its Cyber Quarter which houses a dedicated cyber security testing lab as well as expertise from a range of areas such as law enforcement, legal, finance and technology industries on hand to assist businesses in protecting themselves against online threats. Furthermore, thanks to its links with organisations such as Cyber Scotland and the Scottish Business Resilience Centre (SBRC), Abertay is at the forefront of providing cyber security advice and training throughout Scotland – making this an increasingly attractive vertical for tech companies looking to set up shop in Dundee.


Sustainability and greentech
The MSIP has brought numerous sustainability-focused startups to Dundee via their accelerator programme, which could potentially lead to the creation of new sustainable technologies and businesses within the city. Additionally, Dundee's commitment to incorporating sustainability measures into existing infrastructure has attracted the attention of investors.
Creative
Dundee boasts an impressive creative sector due to its proximity to world renowned educational institutions such as Duncan of Jordanstone College and its vibrant cultural life, primarily exemplified by the presence of the V&A Museum. The V&A have previously run Design for Business accelerators, focussing on design thinking and innovative approaches to problem solving. Again, this vertical lends itself to innovation due to prominence of design thinking and cross over with mixed reality, animation and immersive design with tech.

Key industries
Fintech
Edinburgh's fintech sector has flourished as a vibrant hub for financial technology innovation, benefiting from the city's rich financial history and strong ties to traditional finance. Supported by renowned universities and a collaborative culture, the sector has attracted a diverse range of fintech companies, leveraging technology to revolutionise payments, banking, and insurance. Notable successes, such as FreeAgent and Money Dashboard, have bolstered Edinburgh's reputation, while industry collaborations further fuel its growth, making it a leading global fintech destination.


TravelTech
The traveltech sector in Edinburgh is a lively and innovative ecosystem, leveraging technology to enhance the travel and tourism industry. With a strong talent pool, a supportive ecosystem, and a focus on collaboration, Edinburgh continues to drive advancements in personalised travel experiences, streamlined booking processes, and immersive virtual exploration. The city's traveltech cluster is poised for further growth, attracting both domestic and international attention as a hub of travel innovation.
LawTech
Edinburgh's lawtech cluster has emerged as a dynamic and thriving hub for innovation and technology-driven solutions in the legal sector. Building on the city's strong legal heritage and renowned universities, the cluster brings together legal professionals, technology experts, and entrepreneurs to drive advancements in legal services and access to justice. Edinburgh's lawtech ecosystem benefits from a collaborative culture, with initiatives like legal tech meetups and accelerators fostering networking and knowledge exchange. Startups and established companies in areas such as legal research, contract management, and legal analytics are leveraging technologies like artificial intelligence, machine learning, and blockchain to streamline processes, improve efficiency, and enhance legal outcomes. Supported by government initiatives and industry collaborations, Edinburgh's lawtech cluster is positioned as a leading global destination for legal technology innovation.


GreenTech
Edinburgh's greentech cluster is a thriving hub for sustainability and transformation in the field of green technology. With a focus on addressing environmental challenges and promoting sustainable practices, the sector brings together a diverse range of stakeholders, including researchers, entrepreneurs, investors, and policymakers. Edinburgh's strong academic institutions and research centres provide a solid foundation for cutting-edge developments in renewable energy, clean transportation, waste management, and resource efficiency. Collaborative initiatives, incubators, and funding programs support the growth of greentech startups, fostering a culture of knowledge sharing and collaboration. Edinburgh's greentech cluster is playing a pivotal role in driving the transition towards a greener and more sustainable future, positioning the city as a leading global player in the greentech sector.
Key industries
Through Techscaler and other programmes and CodeBase we support startups in every sector, however we’ve highlighted below some key industries that are significant in this region and have an existing foundation here.
Education
Lorem ipsum dolor sit amet, consectetur adipiscing elit. Aenean quis tempus quam. Proin rhoncus pretium lorem, vel convallis eros viverra et. Aenean vitae dui lobortis enim euismod ultrices. Aenean sed elit facilisis, volutpat neque sed, sollicitudin sem.


Engineering
Lorem ipsum dolor sit amet, consectetur adipiscing elit. Aenean quis tempus quam. Proin rhoncus pretium lorem, vel convallis eros viverra et. Aenean vitae dui lobortis enim euismod ultrices. Aenean sed elit facilisis, volutpat neque sed, sollicitudin sem.
Key industries
Techscaler we support startups in every sector, however, we’ve highlighted below some key industries that are significant in this region and have an existing foundation here.
Energy
The Highlands and Islands continue to lead the way in terms of green energy conversion in response to the global climate emergency within the UK, with large offshore and onshore investments in wind turbines and their supporting infrastructure, as well as the development of wave and hydroelectric generation. Investment in infrastructure for connectivity to the national grid has brought with it sound levels of economic reward and greater levels of broadband connectivity across the region, opening up even more economic channels for development, such as the tech sector. Recent investment into the Inverness and Cromarty port authorities in the form of a Green Freeport seeks to repurpose manufacturing yards previously utilised for oil into a just transition towards the green economy and provides a significant opportunity for local tech development to support the sector.


Blue Economy
Historically focussed around fishing and the oil and gas sectors, the Blue Economy within the Highlands and Islands has developed rapidly in recent decades to encompass a far more wide-ranging number of industry verticals such as: Aquaculture, Seafood Processing, Marine Energy and Renewables, Oil & Gas Decommissioning, Seabed Mining, Marine Biotechnology & Bioprocessing, Marine Environmental Services, Maritime Transport and Shipbuilding and Marine & Coastal Tourism. With a coastline larger than that of France, there is considerable resource that the Highlands and Islands can make use of and strategic policies from regional development organisations are seeking to capture the advantage that the region has particularly in energy and renewables; environmental services and aquaculture. The revitalisation of the former oil and gas yards in the region is allowing for considerable expansion of the green energy economy, affording many opportunities in the tech solutions required to ensure efficiency and global reach. The region holds world-leading research institutes around key industries within the economic sector such as: SAMS UHI (Scottish Association for Marine Science) in Oban, The Bryden Centre of UHI Executive Office, UHI Shetlands Marine Sciences and Technology research centre, Robert Gordon University’s Orkney Research and Innovation Campus and Heriot-Watt’s Orkney Campus, all producing world-leading research at the cutting edge of just transitions away from oil and gas within the region.
Food and Drink
A burgeoning sector of the Scottish Economy, the Highlands and Islands are well placed within this vertical, producing quality products throughout the region with a strong competitive advantage due to their provenance. With products from Distilling and Brewing, Aquaculture production, Fisheries and Farming, many of these are processed and packaged locally for distribution within worldwide markets. Emerging technologies are playing a major role within this sector, with collaborative working from academia, regional economic development agencies and national stakeholders helping to improve competitiveness and growth.


Tourism
The tourism sector has historically been - and continues to be - a large industry within the region, with pre-Covid spending of £1.5bn annually by visitors to the Highlands and Islands. The sector has been impacted significantly due to the pandemic, but now sees a strong resurgence with visitor numbers, and tourism businesses increasing dramatically. To that end, considerable investment in the sector has been made by Highlands and Islands Enterprise (HIE), not least for organisations to take advantage of innovative technological solutions to overcome the challenges presented by the pandemic, Brexit impacts on recruitment to the area and the prevailing economic conditions that have impacted the sector. Technology placement programmes from HIE are aiding organisations in their adoption of digital transition and this affords the tech sector significant possibilities in helping the sector to meet the emerging challenges that they face, as well as aiding visitors to make the most of their time within the region.
Life Sciences
With more than 80 Life Sciences operating within the Highlands and Islands, employing approximately 2500 people, this is an often hidden, but large and very productive sector for the region, which is afforded significant support from Highlands and Islands Enterprise. With recent investments in a new Life Sciences Innovation Centre within Inverness to further collaboration between industry and academia, the sector is set to continue to grow. The vertical provides, in many cases, organisations with a high growth mindset, international outlook and high-wage positions in the local economy. Often sitting at the edge of technological development in their fields, the crossovers with the tech sector are evident and with continued growth comes a continued requirement for tech solutions to aid in the development of Life Sciences solutions.


Space
Possibly the most exciting and eye-catching industry sector to have emerged within the Highlands and Islands, the unique geography of the region provides a strategic location for low earth orbits with both polar and sun-synchronous orbits possible. Of the 8 proposed Spaceports within the UK, 6 are within Scotland and 5 of those within the Highlands and Islands region. The industry is drawing attention from multinational, national and local companies alike, with the Scottish Government and local regional partners seeing this as a key strategic driver within rural Highlands Economies. Organisations such as Lockheed Martin and Orbex have been provided considerable support to facilitate the construction of launch and support sites for this new industry vertical for the region, offering definitive opportunities for local organisations to add to the more than 300 companies currently operating in Scotland’s Space sector. Across much of the sector within the region, the drive to be carbon neutral is a key focus, offering many potential crossovers to the Greentech sector.
Key industries
Through Techscaler and other CodeBase programmes we support startups in every sector, however we’ve highlighted below some key industries that are significant in this region and have an existing foundation here. The existing investor landscape in Aberdeen and the North East does tend to focus on the energy industry.
Energy
Aberdeen has long been renowned as a global energy hub, critical in terms of the UK’s energy security and in terms of energy incumbents leading the energy transition. The oil and gas energy has loomed large in the region, and with the increasing demand for a “just” transition, the pressure is on for organisations to innovate and decentralise.


Agriculture and Agritech
North East Scotland’s food, drink and wider agriculture sector are an integral part of the North East Economy and account for 20% of Scotland’s food and drink production, in a region that accounts for 10% of Scotland’s population. The primary products are beef, pork, lamb and malting barley. Agritech is a significant opportunity as the sector strives to double output and exports by 2030, as well as increasing productivity.
Fishing
Fishing has played a significant role in the history of the North East of Scotland. The two largest commercial fishing ports in Scotland and indeed the UK are in Peterhead and Fraserburgh and with half of Scotland’s fish landings being made in the North East it is another sector that makes a significant contribution to Scotland’s economy. Peterhead is Europe’s largest fishing port with over 151 million tonnes of fish landed there in 2021, over 50% of the total tonnage landed in Scotland.Technological applications in fishing revolve around more efficient location of stocks as well as trading landed stock more effectively in order to reduce waste.

Life Sciences
The North East is home to leading life sciences research in biologics and a distinct cluster of clinical-stage biotech companies. The region’s goal is to harness these strengths and related asset base to develop one of the most exciting commercial life sciences clusters in the world. ONE BioHub Aberdeen is the new home for life sciences in North East Scotland. The intention is for it to be the place for researchers, innovators and entrepreneurs to translate world-leading science to the marketplace.
Health & Social Care
NHS Grampian is one of the fourteen regional health boards of NHS Scotland. It provides healthcare services to Aberdeen City, Aberdeenshire, and Moray Health & Social Care Partnerships. With 17,000 staff across multiple locations and an ageing population in the region the health board faces multiple challenges particularly around recruitment and retention of staff. Technology will play a crucial role in improving the efficient delivery of care, maximising productivity and improving preventative and responsive care for people in the region.


Law
The North East has a varied legal sector with a number of law firms that offer services in commercial, family, employment and property law. Activity in the energy sector is strong as you would expect with a number of companies specialising in servicing the energy sectors requirements. Lawtech is an undoubted opportunity to engage with legal companies in the North East.
Travel & Tourism
The North East of Scotland is an increasingly popular tourist destination that has seen considerable advances in marketing effort in this sector in recent years. There are a number of attractions including castles and museums which complement the region's fine coastal and mountain landscapes. Tourism generates in excess of £1 billion to the local economy and with an international airport located in Aberdeen and a newly opened cruise ship facility at the new Aberdeen South Harbour there is significant potential to grow this sector.Technology will help consumers continue to engage with content and improve their understanding of what’s on offer in the North East for visitors.

Key industries
Through Techscaler and other CodeBase programmes we support startups in every sector, however we’ve highlighted below some key industries that Through Techscaler and other CodeBase programmes we support startups in every sector, however we’ve highlighted below some key industries that are significant in this region and have an existing foundation here. The existing investor landscape in Aberdeen and the North East does tend to focus on the energy industry.are significant in this region and have an existing foundation here. The existing investor landscape in Aberdeen and the North East does tend to focus on the energy industry.
Agriculture
Agriculture is a primary industry of the South of Scotland. In 2019, Scotland's agriculture industry contributed around £1.3 billion to the Scottish economy and employed 67,000 people. Scottish Dairy accounts for 9% of UK milk production and in 2019, there were 843 dairy farms in Scotland with a herd of 50 or more dairy cattle. Over 65% of dairy herds in Scotland are based in SW Scotland, and the industry contributes a total value of £800m to the Scottish economy.[1] The Digital Dairy Chain project is supporting innovation and the digital transformation of the sector, and the Digital Growth Grant, delivered by Barclays Eagle Labs and CodeBase is supporting innovation in the agricultural sector.
[1] https://www.gov.scot/publications/dairy-sector-climate-change-group-report-2/pages/5/


Food, Drink & Hospitality
North East Scotland’s food, drink and wider agriculture sector are an integral part of the North East Economy and account for 20% of Scotland’s food and drink production, in a region that accounts for 10% of Scotland’s population. The primary products are beef, pork, lamb and malting barley. Agritech is a significant opportunity as the sector strives to double output and exports by 2030, as well as increasing productivity.
TravelTech
Fishing has played a significant role in the history of the North East of Scotland. The two largest commercial fishing ports in Scotland and indeed the UK are in Peterhead and Fraserburgh and with half of Scotland’s fish landings being made in the North East it is another sector that makes a significant contribution to Scotland’s economy.Peterhead is Europe’s largest fishing port with over 151 million tonnes of fish landed there in 2021, over 50% of the total tonnage landed in Scotland.Technological applications in fishing revolve around more efficient location of stocks as well as trading landed stock more effectively in order to reduce waste.


Creative Industries
The North East is home to leading life sciences research in biologics and a distinct cluster of clinical-stage biotech companies. The region’s goal is to harness these strengths and related asset base to develop one of the most exciting commercial life sciences clusters in the world. ONE BioHub Aberdeen is the new home for life sciences in North East Scotland. The intention is for it to be the place for researchers, innovators and entrepreneurs to translate world-leading science to the marketplace.
Space
NHS Grampian is one of the fourteen regional health boards of NHS Scotland. It provides healthcare services to Aberdeen City, Aberdeenshire, and Moray Health & Social Care Partnerships. With 17,000 staff across multiple locations and an ageing population in the region the health board faces multiple challenges particularly around recruitment and retention of staff. Technology will play a crucial role in improving the efficient delivery of care, maximising productivity and improving preventative and responsive care for people in the region.

What support is available to you in Edinburgh & Lothians?
The Team

Head of Regional Engagement
,
Paul Mitchell
, is your first point of contact for the region. They’re here to help you find the right support through joining the Techscaler community and becoming a Techscaler member, and grow regional participation in the Techscaler programme.






Workspace
Our CodeBase Edinburgh hub, at 37a Castle Terrace, EH1 2EL, brings together a vibrant and welcoming community, an amazing array of events, and offers a variety of workspace options for all stages and sizes of startups.
Our CodeBase Edinburgh hub, at 37a Castle Terrace, EH1 2EL, brings together a vibrant and welcoming community, an amazing array of events, and offers a variety of workspace options for all stages and sizes of startups.
Hot Desking
Hot Desking is available Monday - Friday, 9am - 5pm (£5 per half day £10 per day, or £50 per month). You can choose a seat in the designated hot desking area, and use the Wi-Fi. There is no need to prebook, you can just pop along on the day. For hotdeskers we also offer meeting rooms for 2 hours for free on an ad hoc basis, if you need a quieter space for a more important meeting. With that in mind, we’re also very happy for people to take calls and team meetings in the hotdesking space. This is a good option and opportunity for people working in tech who want to chat with others in the industry.
Co-working
Co-working - £120 (ex VAT) per month, a fixed desk in one of our co-working spaces. Benefits include: a registered address, utilities, Wi-Fi, access to meeting & event spaces, your own pass, free use of event space and out normal working hours (9 am -5 pm) access to the building, and community membership. This is a good option for founders who are bootstrapped or have some seed investment. It is also suitable for existing companies that are starting satellite locations. The Stirling hub is a great location as businesses within benefit from Glasgow and Edinburgh clients but identity-wise are tied to neither.
Office Space
Office Space – private office spaces for 2 to 70 persons. Prices are dependent on the size of space you need and include rent, utilities (internet, water, electricity), facilities (access to meeting & event spaces, common spaces, kitchen.
TS Network Offering
Free use of Hot Desking for Techscaler members with long-term occupancy of other CodeBase hubs, e.g. Co-workers and Office Space tenants. Process is WIP; but, for now, email the reception team stirling@thisiscodebase.com to let them know that a community member would like to use the Hot Desking space, cc-ing the community member in for direct contact.
Hot Desking
Drop in and pick your desk in our open-plan space with great Wi-Fii, Tasty Buns café, table tennis and soft seating areas. This is a great place for those who like a bit of buzz and background noise while they work, who want to chat with others in our community, or who are just looking for a space to use a few times a week.
No advance booking and no tour of the space needed, just turn up and pay on the day (subject to availability).
Access: Monday - Friday, 9am - 5pm
Cost: £10 per day/£50 per month (inc. VAT)
Benefits: Wi-Fi, café, video call booth, networking and communityCo-working
Co-working - £120 (ex VAT) per month, a fixed desk in one of our co-working spaces. Benefits include: a registered address, utilities, Wi-Fi, access to meeting & event spaces, your own pass, free use of event space and out normal working hours (9 am -5 pm) access to the building, and community membership. This is a good option for founders who are bootstrapped or have some seed investment. It is also suitable for existing companies that are starting satellite locations. The Stirling hub is a great location as businesses within benefit from Glasgow and Edinburgh clients but identity-wise are tied to neither.
Office Space
Office Space – private office spaces for 2 to 70 persons. Prices are dependent on the size of space you need and include rent, utilities (internet, water, electricity), facilities (access to meeting & event spaces, common spaces, kitchen.
Event Spaces
Please contact the events team to place a room booking or chat to your local HRE or Community Manager. Rates for hire are detailed below:
Space Tenant Duration Price Event No Full Day (9am-5pm) £440 (excl. VAT) Event No Half Day (4 hours) £260 (excl. VAT) Event No Evening (5.30pm-8pm) £315 (excl. VAT) Event Yes Half Day (4 hours) £220 (excl. VAT) Event Yes Full Day (9am-5pm) £130 (excl. VAT) Event Yes Evening (5.30pm-8pm) £150 (excl. VAT) External Meeting Room Hire
Please contact the reception team to place a room booking or chat to your local HRE or Community Manager. Rates for hire are detailed below:
Room Duration Price Board Room (Meadow/Leith Links) Hourly Rate £30 (excl. VAT) Board Room (Meadow/Leith Links) Day Rate £180(excl. VAT) Any other meeting room Hourly Rate £20 (excl. VAT) Any other meeting room Day Rate £120 (excl. VAT)
Hot Desking
Hot Desking is available Monday - Friday, 9am - 5pm (£5 per half day £10 per day, or £50 per month). You can choose a seat in the designated hot desking area, and use the Wi-Fi. There is no need to prebook, you can just pop along on the day. For hotdeskers we also offer meeting rooms for 2 hours for free on an ad hoc basis, if you need a quieter space for a more important meeting. With that in mind, we’re also very happy for people to take calls and team meetings in the hotdesking space. This is a good option and opportunity for people working in tech who want to chat with others in the industry.
Co-working
Co-working - £120 (ex VAT) per month, a fixed desk in one of our co-working spaces. Benefits include: a registered address, utilities, Wi-Fi, access to meeting & event spaces, your own pass, free use of event space and out normal working hours (9 am -5 pm) access to the building, and community membership. This is a good option for founders who are bootstrapped or have some seed investment. It is also suitable for existing companies that are starting satellite locations. The Stirling hub is a great location as businesses within benefit from Glasgow and Edinburgh clients but identity-wise are tied to neither.
Office Space
Office Space – private office spaces for 2 to 70 persons. Prices are dependent on the size of space you need and include rent, utilities (internet, water, electricity), facilities (access to meeting & event spaces, common spaces, kitchen.
TS Network Offering
Free use of Hot Desking for Techscaler members with long-term occupancy of other CodeBase hubs, e.g. Co-workers and Office Space tenants. Process is WIP; but, for now, email the reception team stirling@thisiscodebase.com to let them know that a community member would like to use the Hot Desking space, cc-ing the community member in for direct contact.
Hot Desking
Unlimited hotdesking membership with 24hr access 7 days a week for £135pcm
8 days pcm hotdesking membership (bookable as 16 half days between 09:00 & 17:00 Mon-Fri) £100pcmCo-working
Fixed desk within the co-working space for £175pcm, providing unlimited 24:7 access and a secure lockable unit.
Fixed banks of desks are available for operating your own hotdesking operation, POA
Small 2-3 person office spaces, perfect for smaller startups, are available within the hub. Please get in touch for further details.
Hot Desking
Hotdesking is available Monday-Friday 9am-5pm (£10 per day or £100 per month).
Co-working
Coworking - a fixed desk in one of our coworking spaces - for £150 per month.
Office Space
Office space - private office spaces from 2-21 persons, starting from £200 per desk per month including rent, utilities and facilities
Startup Co-working
Access coworking space for £250 per month (£3,000 annually) for up to 2 staff members
Meeting rooms
As part of the coworking membership, tenants will have access to use of meeting rooms and event spaces free of charge. For Codebase members who are not paying members of the space, the following rates apply for bookings:
Space Capacity Duration Price Small meeting room 3 - 4 Full Day (9am-5pm) £95 (excl. VAT) Small meeting room 3 - 4 Half Day (4 hours) £47.50 (excl. VAT) Medium meeting room up to 8 Full Day (9am-5pm) £130 (excl. VAT) Medium meeting room up to 8 Half Day (4 hours) £65 (excl. VAT) Large meeting room up to 15 Full Day (9am-5pm) £195 (excl. VAT) Large meeting room up to 15 Half Day (4 hours) £97.50 (excl. VAT) Event space 50 seated,
80 standingHalf Day (4 hours) £260 (excl. VAT)
Events & Meetups
Community Support
We work with partners xxxxx to provide support in the area. Join us in the

Other regions

Frequently asked questions
Everything you need to know about Techscaler. If you can’t find the answer to your question here please get in touch.
Lorem ipsum dolor sit amet, consectetur adipiscing elit. Praesent mauris arcu, dictum vel suscipit sed, gravida et quam. Cras eu finibus felis, eu sodales nisl. Nullam elementum odio a velit.
A single desk of space for developers, creatives, entrepreneurs, designers, product managers, markers and digital marketers to drop in. We like people who want to collaborate with our community and make awesome things happen.
Lorem ipsum dolor sit amet, consectetur adipiscing elit. Praesent mauris arcu, dictum vel suscipit sed, gravida et quam. Cras eu finibus felis, eu sodales nisl. Nullam elementum odio a velit.
Join Techscaler
If our education courses are of interest to you, apply for Techscaler membership. Membership is for people working in startups who are at all stages of the startup journey, from ideation through to scaling phase, based in Scotland, and with ambitions to grow their business. Fill in the application form and Team Techscaler will get back to you as soon as possible to let you know your suitability for Techscaler membership and benefits available to you.
You can also keep up to date with our tech events and sign up to receive the latest news from Techscaler and the Scottish tech ecosystem.



